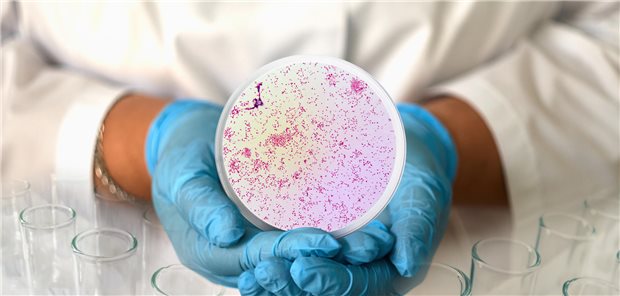
Häufung von Tetrazyklin-Resistenzen – die Kehrseite der Doxy-PEP? Eine Frau hält einen Abstrich von Gonokokken in die Kamera.

Themenseite Geschlechtskrankheiten
Themenseite - Geschlechtskrankheiten
Wirkstoff-Wechselwirkungen
Antiretrovirale Therapie bei HIV: Auf diese Arzneimittelinteraktionen sollten Sie achten
Gehen oft Hand in Hand
Fettleber-Erkrankungen nehmen zu bei Patienten mit HIV
28.11.2025
|
Tipps für die Verordnung
Häufung von Tetrazyklin-Resistenzen – die Kehrseite der Doxy-PEP?
05.11.2025
|
Wirkstoff-Wechselwirkungen
Antiretrovirale Therapie bei HIV: Auf diese Arzneimittelinteraktionen sollten Sie achten
Podcasts
„ÄrzteTag“-Podcast
Was läuft schief bei der HIV-Prophylaxe, Dr. Römer?
Meinung